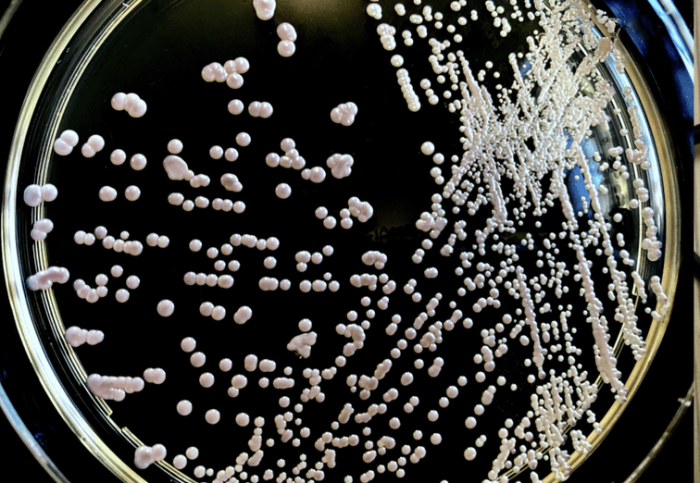
念珠菌感染症狀

目录
為什麼會發生念珠菌感染?了解念珠菌感染原因、症狀、診斷方式及治療方法很重要。念珠菌感染症狀包括搔癢與異常分泌物,診斷需透過檢驗,治療使用抗真菌藥物,預防念珠菌感染需保持乾燥與良好衛生習慣。完整掌握念珠菌感染知識,有效對抗與預防復發。
一、念珠菌感染原因
念珠菌是人體正常菌群的一部分,通常存在於皮膚、口腔、消化道和陰道等部位。當人體內環境平衡被破壞或免疫力下降時,這些常駐菌可能過度繁殖導致感染。
1.1 念珠菌感染原因:微生物學基礎
念珠菌屬包含超過150種真菌,其中約20種可導致人類感染。白色念珠菌具有以下致病特性:能形成假菌絲(pseudohyphae)和菌絲(hyphae),分泌水解酶(如蛋白酶和磷脂酶),形成生物膜(biofilm),這些特性增強其侵襲力和對抗宿主防禦的能力。
1.2 念珠菌感染原因:致病機轉
念珠菌感染發展取決於病原體毒力因子和宿主防禦間的平衡。主要致病機轉包括:粘附於宿主上皮細胞,分泌侵襲性酶類,形態轉變(酵母態與菌絲態轉換),以及逃避宿主免疫反應的能力。當宿主局部或全身防禦機制受損時,這些特性共同促成感染發生。
1.3 念珠菌感染原因:宿主防禦機制
健康個體對念珠菌有多重防禦:完整皮膚和黏膜屏障,正常菌群競爭,先天免疫(如中性粒細胞、巨噬細胞和補體系統),以及適應性免疫(Th1型細胞免疫反應)。任何影響這些防禦系統的因素都可能增加感染風險。
二、高危行為與外部誘因
多種內在和外在因素可破壞微生態平衡,促使念珠菌過度生長。這些誘因可大致分為局部和全身性兩大類。
2.1 局部誘因
陰道念珠菌感染常見局部誘因包括:頻繁使用抗生素(破壞正常菌群),高雌激素狀態(如懷孕或使用口服避孕藥),使用含香料衛生產品,穿著不透氣內衣,以及不當陰道灌洗。口腔念珠菌病則與配戴義齒、吸入性皮質類固醇使用、吸菸等因素相關。
2.2 全身性誘因
重要全身性因素包括:糖尿病(尤其血糖控制不佳者),免疫抑制狀態(HIV感染、化療患者、器官移植後免疫抑制劑使用),營養不良(特別是鐵、鋅、葉酸缺乏),長期使用廣效抗生素,以及系統性皮質類固醇治療。這些狀況削弱宿主防禦,創造有利念珠菌生長的環境。
2.3 行為相關風險
某些行為模式增加感染風險:性行為可能改變陰道環境並傳播念珠菌(儘管不被視為性傳染病),不良口腔衛生促進口腔定植,長期使用導尿管增加泌尿系統感染機會,靜脈注射藥物可能導致血行性感染。
三、念珠菌感染症狀
念珠菌感染症狀因感染部位而異,從局部黏膜感染到危及生命的全身性感染皆有可能。以下分述常見臨床表現。
3.1 黏膜皮膚感染
口腔念珠菌病(鵝口瘡)表現為乳白色斑塊,刮除後可見基底部紅腫;陰道炎主要症狀為劇癢、白色濃稠分泌物及外陰紅腫;龜頭炎則常見包皮及龜頭紅斑伴白色分泌物。皮膚念珠菌感染好發於潮濕皺褶處,呈現衛星狀分布的紅色丘疹和膿皰。
3.2 侵襲性感染
在免疫低下患者可能發展為嚴重感染:食道炎導致吞嚥疼痛,念珠菌血症引起發熱和敗血症表現,內眼炎造成視力模糊,心內膜炎可導致心衰竭和栓塞現象。這些情況需要緊急醫療介入。
3.3 慢性黏膜皮膚念珠菌病
這是一種罕見的T細胞功能缺損疾病,表現為持續或反覆的皮膚、指甲和黏膜感染,常伴隨內分泌異常(如甲狀腺功能低下)。患者多數在幼年發病,需要長期抗真菌治療。
四、念珠菌感染診斷
準確診斷念珠菌感染須結合臨床評估和實驗室檢查,不同感染部位需採用相應採樣技術。
4.1 臨床診斷
典型黏膜皮膚感染常可根據臨床表現診斷。陰道炎患者需評估分泌物理學特性(如pH值通常
4.2 實驗室檢查
直接鏡檢(10% KOH處理或革蘭染色)可觀察酵母菌和假菌絲;培養鑑定是確診標準,尤其對侵襲性感染。新興技術如基質輔助激光解吸電離飛行時間質譜(MALDI-TOF MS)和分子檢測可加速菌種鑑定。
4.3 特殊情況評估
對復發性或嚴重感染患者,需排查潛在誘因:檢測空腹和餐後血糖評估糖尿病可能,HIV血清學檢查排除免疫缺陷,必要時評估腎上腺和甲狀腺功能。對疑似侵襲性感染者,應進行血液培養、眼底檢查和適當影像學評估。
五、念珠菌感染治療
念珠菌感染治療需綜合考慮感染部位、嚴重程度、宿主免疫狀態和當地抗藥性模式,採取個體化方案。
5.1 局部抗真菌藥物
無併發症的陰道炎可選用陰道栓劑(如克霉唑、咪康唑)1-7天;口腔鵝口瘡常用制黴菌素懸液或克霉唑錠;皮膚感染可使用局部唑類或丙烯胺類藥膏。這些藥物直接作用於感染部位,全身吸收少,副作用輕微。
5.2 全身性抗真菌藥物
氟康唑是大多數黏膜感染的首選口服藥物;伊曲康唑對某些非白色念珠菌效果更佳;棘白菌素類(如卡泊芬淨)適用於侵襲性感染;兩性黴素B保留用於嚴重感染或耐藥菌株。治療療程從單次劑量到數週不等,視感染嚴重程度而定。
5.3 難治性感染處理
對復發性陰道念珠菌病(每年≥4次),建議初始治療後進行6個月的維持性治療(如每週氟康唑);耐藥感染需根據藥敏試驗調整方案,可能需聯合治療;免疫功能低下患者往往需要更長療程和更高劑量。
六、念珠菌感染預防
有效預防需針對易感因素進行干預,包括生活方式調整和特定族群化學預防。
6.1 一般預防建議
保持感染部位清潔乾燥:穿著透氣棉質內衣,避免長時間穿著濕泳衣或運動服;控制基礎疾病如糖尿病;避免不必要的抗生素使用;維持均衡飲食以支持免疫功能;適當處理義齒和口腔衛生。
6.2 高風險族群預防
對接受化療或造血幹細胞移植患者,可考慮氟康唑或米卡芬淨預防;HIV感染者CD4
6.3 復發預防策略
復發性陰道炎患者應避免使用含香料衛生產品;性交後排尿和清洗可能減少復發;益生菌(含乳酸桿菌)補充可能幫助維持陰道微生態平衡,但證據強度仍有限。教育患者識別早期症狀及適當自我管理也很重要。
感染說團隊溫馨提醒:念珠菌感染涉及複雜的宿主-微生物相互作用。了解其病因學和危險因素有助於臨床醫師精準診斷和有效治療。對於免疫正常個體的局部感染,預後通常良好;但侵襲性念珠菌病仍具高死亡率,強調早期診斷和適當治療的重要性。預防策略應針對可改變的風險因素,尤其在易感族群中。未來研究方向包括開發更快速診斷工具、新型抗真菌藥物和免疫調節療法。
留言討論
發表留言